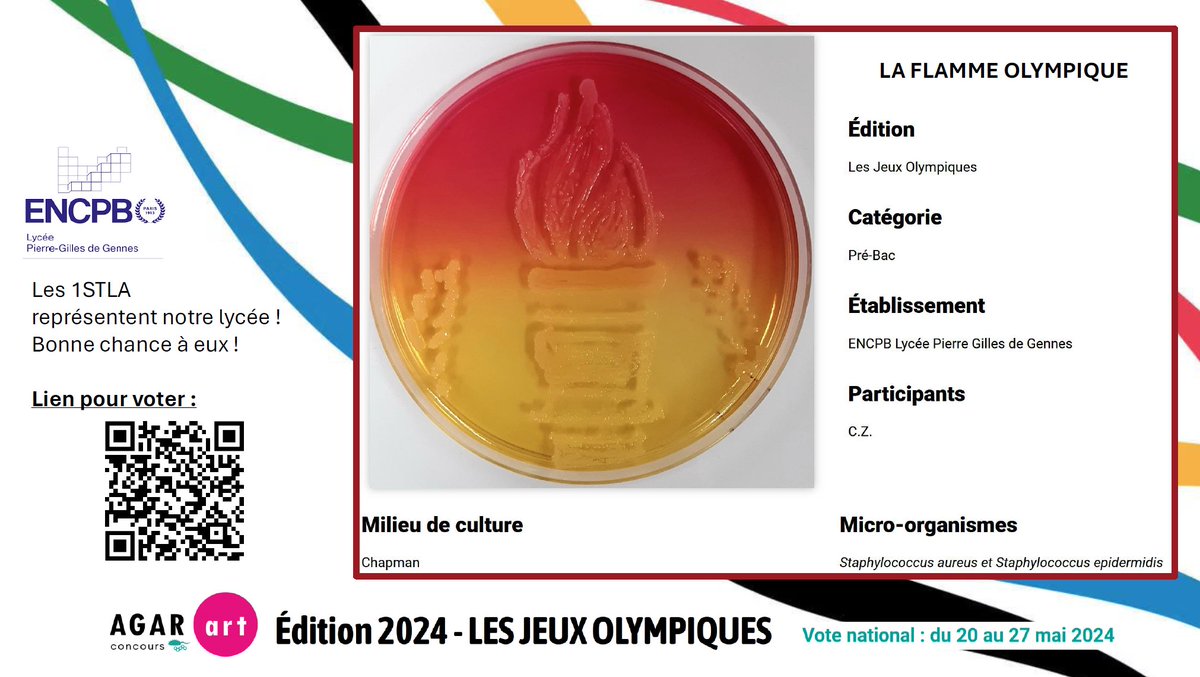
Les 1 #STL #Biotechnologies participent cette année encore au concours national Agar Art.
Bravo à eux et à tous les participants ! Toutes les créations sont cette année encore, magnifiques !
Pour admirer et voter pour l’œuvre du lycée,
 c'est par ici :
 agar-art.alwaysdata.net/la-flamme-olym…

CDI Encpb Lycée Pierre Gilles de Gennes Paris
@cdiencpb
CDI du Lycée Pierre Gilles de Gennes et de l'Ecole Nationale de Physique, Chimie et Biologie de Paris
ID: 1219240600161193984
20-01-2020 12:49:56
881 Tweet
152 Takipçi
141 Takip Edilen




📢 Journée nationale de lutte contre le harcèlement - Sélection de ressources au CDI et en ligne. Mieux comprendre pour réagir et prévenir ! #NAH #nonauharcelement #vivreensemble Documentation académie de Paris Académie de Paris Nora Machure Maxime PEAUDEAU


Intelligence artificielle et données de santé : les élèves volontaires pour la consultation lycéenne assistent à une présentation Espace éthique/IDF Health Data Hub Dialogue, écoute et questionnement éthique seront au programme ! Académie de Paris Documentation académie de Paris Nora Machure Maxime PEAUDEAU


📣 #JPO à l’ENCPB ! Venez découvrir nos formations pré-bac et post-bac ! #orientation #parcoursup Académie de Paris Documentation académie de Paris Onisep


Plongez dans l'histoire avec une exposition retraçant la journée des TleG3 au Camp des Milles ! Au CDI jusqu'aux vacances d’Avril ! Expérience à ne pas manquer pour découvrir le début d'un parcours tragique de milliers de déportés #Histoire #WWII @campdesmilles Académie de Paris


Un très beau texte engagé d'AnneCordier : "Pour que la chance et la joie de s’informer n’aient d’égales que celles d’éduquer aux médias et à l’information" A lire et à partager. Merci Anne ! cultinfo.hypotheses.org/1376

📢Concours Agar Art 2024 ! Venez admirer dans le hall du lycée les œuvres des 1STLA et votez pour votre gélose préférée jusqu'au 29 mars 🗳️ Académie de Paris Documentation académie de Paris #STL #biotechnologies #AgarArt


🚨📆 Rappel du jour : vous avez jusqu'au 3 avril pour confirmer vos voeux sur Parcoursup ☑ Retrouvez notre to-do list en ligne pour ne rien oublier. 🧑🎓⤵️ 📝 To-do list : letudiant.fr/etudes/parcour…


🧫🗳️🧫Venez voter pour votre Agar'Art préféré ! C'est au niveau 3, jusqu'au 29 Mars ! Dur de choisir votre coup de ❤️, tellement les œuvres sont réussies ! A vos bulletins de vote ! Académie de Paris @STL_ST2S_JJ


📢 4 Avril : Journée de l'#environnement organisée par nos éco-délégués 🌎🌳Documentation académie de Paris Académie de Paris ENCPB Paris





📖📝Merci à Nakia en terminale , qui grâce à sa pugnacité et à ESA France , a réussit à faire dédicacer par Thomas Pesquet la formidable Bd « Dans la combi de Thomas Pesquet » de Marion Montaigne ! ⭐️Lire et rêver des étoiles !⭐️ Editions Dargaud


Nous avons décidé de quitter X. Pour continuer à nous suivre, retrouvez-nous sur @cdipgdegennesencpb.bsky.social Académie de Paris ENCPB Paris M. Hérault (Maths - ENCPB) Documentation académie de Paris